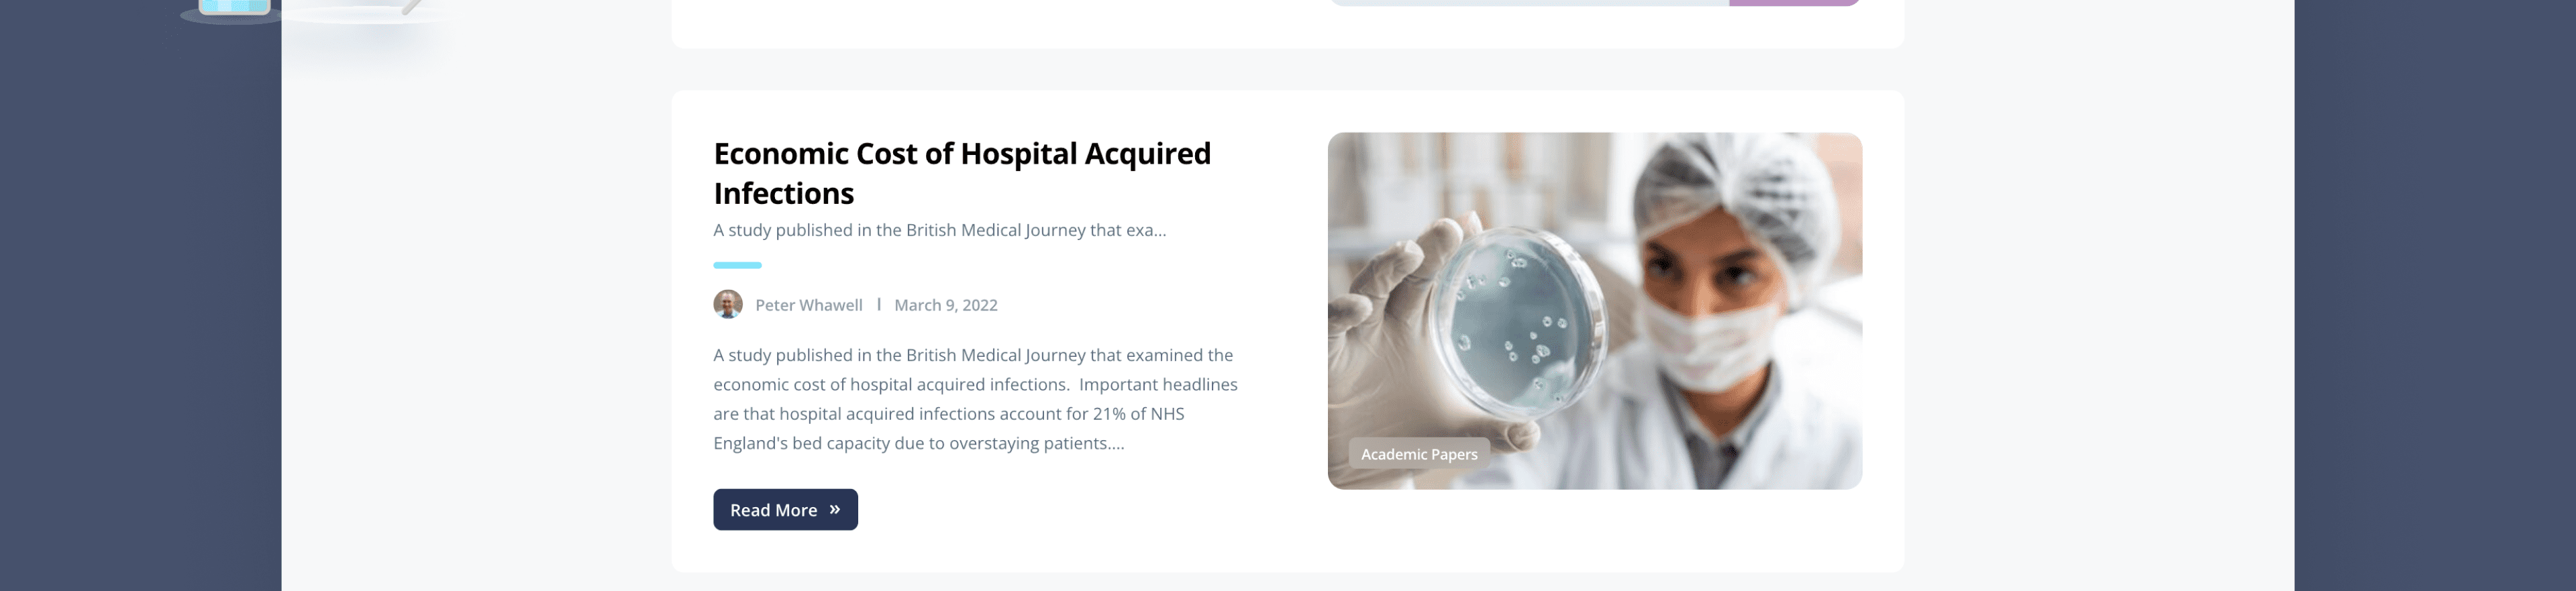
WorldEx Technologies

Proxximos
Proxximos is an innovative digital technology company focused on preventing and controlling communicable diseases. Their mission is to use advanced digital solutions to track pathogen spread, enabling fast, accurate responses and effective prevention. Proxximos develops scalable products for healthcare and corporate environments, public health authorities, and low-income countries. WorldEx Technologies partnered with Proxximos to design and develop a website that reflects their vision and supports their global public health goals.

Our Web Design Portfolio
Our collaborative approach to bespoke website design and development ensures we deliver engaging digital products that resonate with your audience and drive meaningful results.
QuantBlock is a global innovation consultancy specialising in blockchain technology, backed by an experienced team of researchers, innovators and developers.
Konstru is a data management platform built to translate building models across multiple software applications.
Mozart Moving specialises in residential and commercial moving services, including local moves, interstate relocations and office removals.
ImmigrationCases.org is an informational website offering clear, in-depth articles and guides for individuals seeking advice on U.S. immigration cases.
The Iceland24 blog is part of a travel blogging network written by Icelandic locals, helping travellers plan unforgettable trips to Iceland.
Glowboxes is an e-commerce website specialising in high-quality neon products for retail and wholesale customers.







